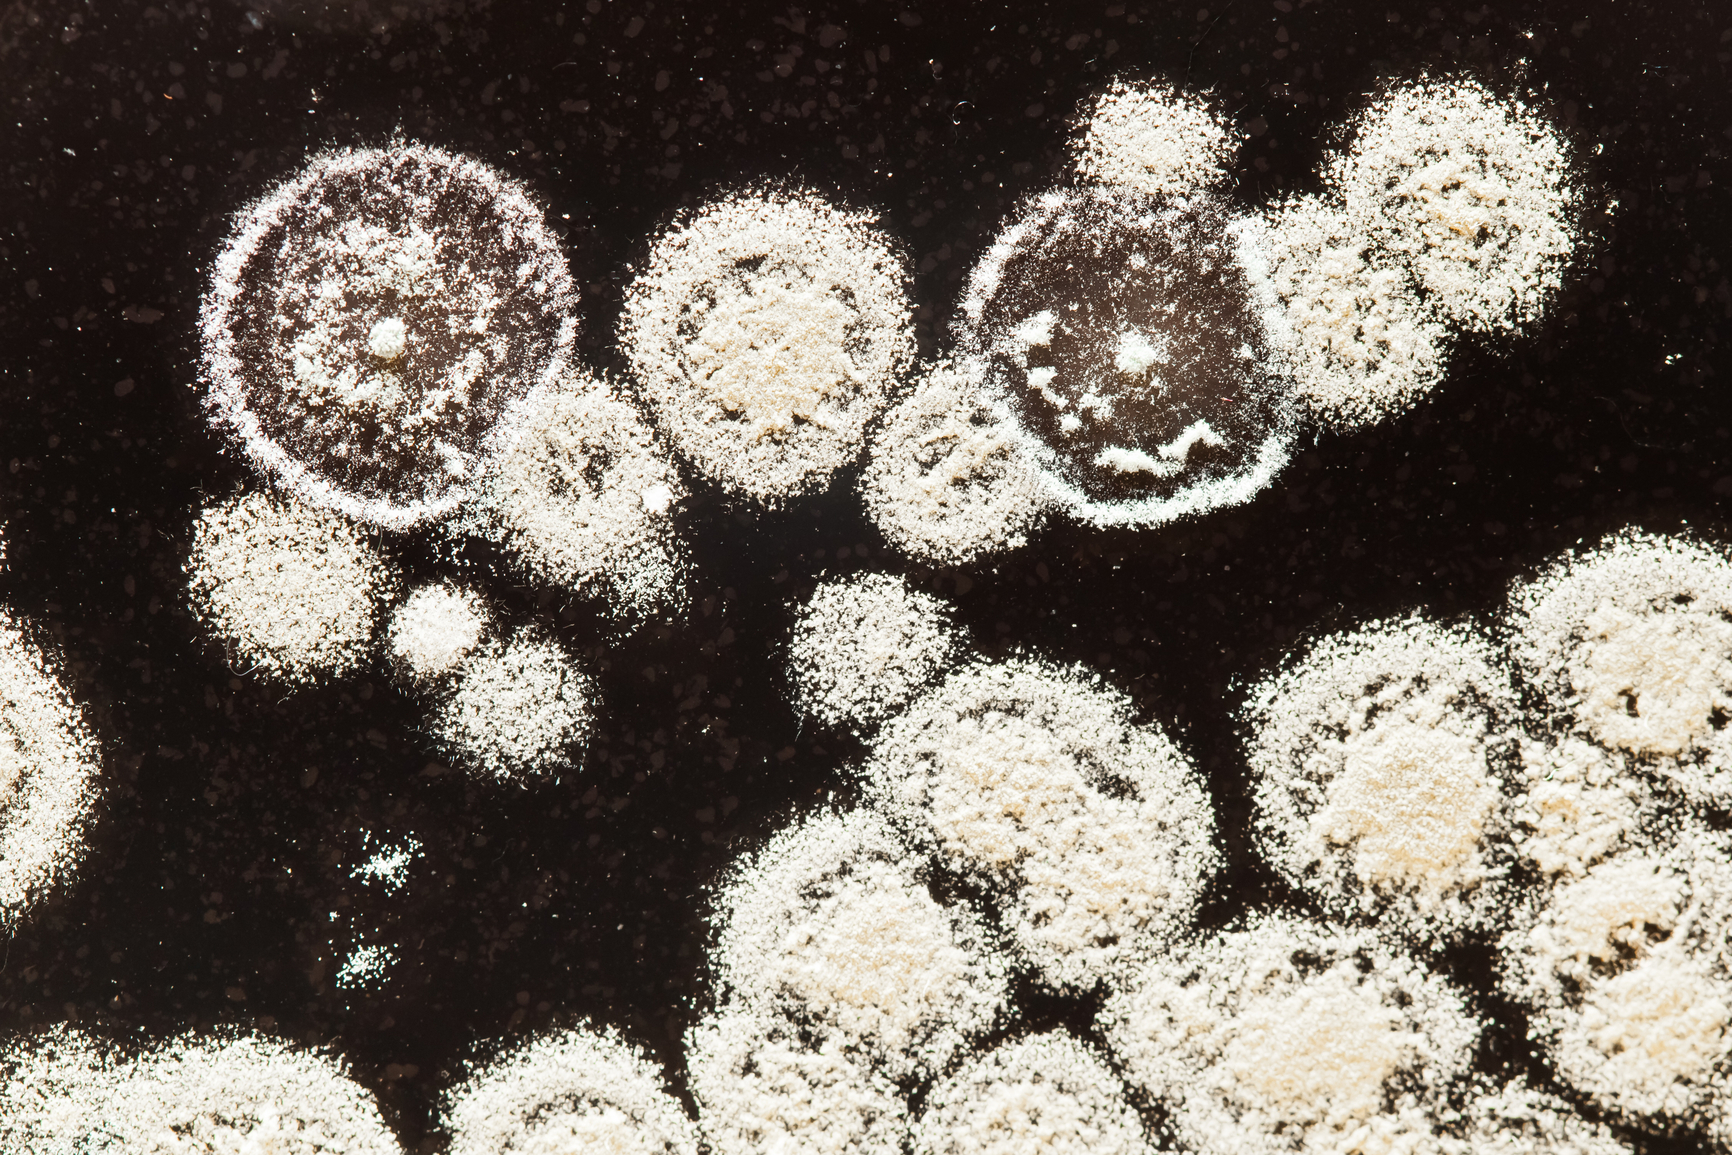

I know, I know, there are many places that already have really great descriptions and information on the equine Digestive system. But the ABCs of Equine Nutrition will be a book when we are done and a book on equine nutrition would not be complete without a review of the Digestive system and how it works. Plus it begins with the letter “D”. So if you are well versed in equine Digestion and how it works then you can wait for our next topic for the letter “D” and that’s Dengie. If not, let’s go!
To keep it simple (and I’m all about that) Digestion is basically the process of making food absorbable by the body to use as energy. It does this by dissolving it and breaking it down into simpler chemical compounds. In the horse this is done through the action of enzymes in the foregut (stomach and small intestine) and fermentation in the hind gut (cecum and large intestine).
When Digestion works properly the nutrients from the broken down feed can be absorbed and provide the fats, carbohydrates, amino acids (protein), vitamin and minerals for the horse to use to live, grow, work, etc. These nutrients can be used right away or stored for future demands.
THE PARTS:
There are nine main parts to the equine Digestive system; the mouth (lips and teeth), the pharynx, the esophagus, the stomach, the small intestine, the cecum, large colon, small colon (known as the large intestine) and the rectum. There are also smaller body parts that are necessary for Digestion and absorption including the tongue, the salivary glands, the pancreas and the liver. The stomach and small intestine (SI) are referred to as the foregut and the cecum, large colon and small colon are the hindgut.

Most of the descriptions I read about equine Digestion focus on the fore and hind gut processes but as you will see, if any part, big or small, are compromised in any way it can really affect your horse’s ability to metabolize its food correctly. For example, a horse with stomach ulcers or an older horse with limited teeth.
I find it helps horse owners understand the process if we take a journey using a horse and a typical meal of forage (hay or grass) and grain. We will follow this meal through the Digestive system and watch as the feedstuff is broken down, absorbed and excreted.
So let’s begin on a typical day. Your horse has been out all night grazing so there is still some food in the Digestive tract which is good because it should never be empty. You bring him into the stall where his breakfast of three pounds of grain and ten pounds of hay is waiting. Of course he heads straight for the feed.

His lips grab the grain pieces and guide it into his mouth where the teeth grind the feed down to a smaller size. When chewing hay or grain it is the molars and premolars that grind and when a horse is eating grass your horse tears it from the ground using the upper and lower incisors.

Your horse will chew 70-90 times per minutes and this act of chewing creates saliva which is paramount to Digestion. The saliva is made up of 99% water but no enzymes for Digestion because the main purpose of saliva is help move the food through the esophagus and to buffer the stomach. The secretion of saliva is stimulated by the scratching of food on the mucous membrane of the inner cheeks. A horse produces saliva in response to chewing, up to 10 gallons a day!
You can imagine how important it is for a horse to have a diet that requires chewing like forage. Sometimes in the case of choke (where a horse bolts its food) the horse tries to swallow before it has chewed enough so it hasn’t produced enough saliva and the food gets stuck in the esophagus.

So your horse has now chewed the food and next it passes through the pharynx, a 6” long sack-like structure where the Digestive and respiratory systems meet. At the point of the pharynx the trachea goes off to the lungs and the esophagus heads to the stomach.
There is a flap of tissue called the soft palate which prevents food from entering the respiratory system and only opens during swallowing. Once the food is past the pharynx it can’t go back up to the mouth, therefore a horse cannot throw-up. So the feed your horse just chewed passes through this sack when he swallows and enters the esophagus.

The esophagus is basically a muscle; a 5 foot long, tubular shaped one. It is lined with squamous epithelium which is basically a barrier that helps a horse get the food down without abrasions from the rough fibrous stuff horses eat. The esophagus moves the food through with a wave-like movement called peristalsis. This wave movement only goes one way ↓ down to the stomach; another reason a horse cannot vomit. The esophagus is merely a portal for the food so virtually no absorption of nutrients happens here.
The esophagus empties into the stomach. The stomach is where the action really starts. For the size of an average horse its stomach is pretty small. Its 2-4 gallons in size, so about the size of that small gas can in your garage.
Your horse’s food passes through and out of the stomach as quickly as 30 minutes. The small size and the rate of passage is one reason why horses that need grain do best when fed small frequent meals instead of large ones, but more about that later.
The equine stomach has two areas; the non-glandular or squamous area where food enters from the esophagus, and the glandular where it meets gastric juices for digestion.
The non-glandular requires a pH of between 6-7 and this area of the stomach can be damaged when the pH is lowered by periods without food and/or diets without enough fiber. The non-glandular area has no mucus layer for protection from gastric juices so it is the most common place that stomach ulcers occur in the horse. Because horses are supposed to eat all the time they produce gastric juices all the time so it’s best if they have something in the stomach for those juices to work on.
The food your horse ate will first hit the bottom part or glandular area of the stomach. The glandular region has a much lower pH (~1-2) and it is lined with a mucus membrane so it is protected from the gastric juices needed for digestion. As more food is eaten, the food will layer in the stomach until it reaches about 2/3 capacity when it will move into the small intestine, even if it’s only partially Digested.
Gastric juice contains hydrochloric acid (HCl) and two enzymes, pepsin and gastric lipase. Proteins are Digested in the stomach by pepsin. Gastric lipase helps start the Digestion of fats into fatty acids and glycerol.Not all the juices that help your horse Digest originate in the stomach; some of the juices come from the pancreas. There is actually a constant secretion of pancreatic juice which help with the breakdown the cellulose (stemmy) material your horse eats. These pancreatic juices also help the hindgut (cecum and colon) to maintain a stable environment which is super important for microbe (bugs that break down forage) survival.

After the stomach your horse’s food will head into the small intestine where the enzymatic Digestion continues. The small intestine is really long at about 70 feet and relatively narrow (3-4”s) think of a thick garden hose and you’ll get the picture. The food moves through the intestines through various muscles which require movement by the horse to help mix it with the juices and keep the foodstuff moving.
Pretty much all of Digestion of the starch, protein, fat, fat-soluble vitamins (A, D, and E), and many minerals contained in feedstuffs occurs in the SI which is probably why it is so long.
There are three sections of the small intestine. The duodenum is right after the stomach and where the food is mixed with the enzymes from the pancreas and the intestinal glands as well as bile from the liver. After the food is neutralized it passes to the jejunum where the nutrients are absorbed, and finally on to the ileum which just connects the small intestines to the large intestine part of the hindgut.
The food in the small intestine is pushed through with those muscular contractions I mentioned earlier. It moves at about 1 foot/minute so it takes anywhere from 45 minutes to two hours for the food to pass through the small intestine depending on meal size, amount of forage and size of horse.
The inner lining of the small intestine is lined with little finger-like projections called villi. Since the villi stick out from the sides of the wall they increase the surface area helping more nutrients be absorbed.

Along the way there are specific enzymes from the glands in the stomach, the pancreas, and the liver that are meant to breakdown certain nutrients. Amylase is responsible for breaking down the starches in the diet into simple sugars and it does a really good job unless there is too much starch in the diet. The starch (soluble carbohydrate) that is absorbed in the SI is either converted into glucose and used for energy or stored as glycogen to be used later. Too much stored glucose turns to fat and can cause metabolic issues.
The enzyme Lipase breaks down and digests the fat, and the enzyme Protease breaks the protein into amino acids. Not all the protein in the food is Digested in the SI though. The protein found in the cell wall of the plant (the fiber part of the diet) travels to the hindgut and is fermented like everything else that ends up there.
The last section of the SI, the ileum, joins the SI to the hindgut. Remember the hindgut actually has three main parts; the cecum, the large colon, and the small colon. Any food that doesn’t get Digested in the foregut ends up in the hindgut. The horse’s Digestive tract is designed to give the non-fiberous feedstuff plenty of time to get Digested before it reaches the hind gut. Everything that reaches the hindgut is Digested through fermentation rather than enzymes.
Fermentation is a process where billions of naturally occurring bacteria and protozoa (together known as microbes) digest the fiber in a horse’s diet. Microbes have three functions; to produce energy through Volatile Fatty Acids, to synthesize B-vitamins and to synthesize amino acids (the building blocks of protein).
Back to the journey of your horse’s dinner. The undigested food from the SI moves into the first part of the hindgut, the cecum, a four foot long organ that lies between the small intestine and the large intestine. It’s more on the right side of the horse and can hold up to 10 gallons of digesta (the food mixed with juices and water).
It takes a long time for the food to leave the cecum (almost 7 hours) so the microbes that are in there have plenty of time to do their job and ferment the fiberous food. Your horse absorbs energy producing volatile fatty acids, amino acids, and B vitamins in the cecum. There are lots of folds in the cecum and the food can get stuck there, especially if there is not enough water in the diet, this is where most impaction colics occur.
The microbes in the hindgut adapt to the specific fiber your horse eats and eventually become a specific population for the type of food that your horse usually eats, which is kind of cool. That is why changes in the diet need to be really slow so the microbes can adjust. If you switch it too fast it can lead to too much fermentation which increases gas production and can lead to gas colic.
When your horse’s stomach feels the presence of food it triggers the cecum to empty its contents of digesta into the large intestine (colon). The large colon extends from the cecum to the small colon and continues the process of microbial Digestion through fermentation.
The large colon is on average about 12 feet long and holds approximately 15 to 20 gallons of feed material and water. The large colon is where absorption of water, electrolytes and short chain fatty acids (the main source of energy in the horse) occur.
The microbes in the hindgut are happiest in a pH of about 6-7. Without enough fiber in the diet, or too much starch and sugar, the microbial balance gets out of whack. When this happens the pH drops and the normal (or good) fiber digesting microbes start to die off while the number of starch digesting microbes increase. The dead microbes are released back into the bloodstream as a poison which causes laminitis.

After the large colon the food your horse ate passes into the small colon which is about nine feet long and holds about four gallons of digested feed and water. The main function of the small colon is to absorb any extra water and return it to your horse’s body. Hopefully most the nutrients are absorbed and the small colon prepares the waste material into small balls of feces.
The last two parts of the equine Digestive tract are the rectum and the anus. The rectum is one foot long and it connects the small colon to the anus.
The fecal balls pass through the rectum and out the anus. Lots of them. About 50 pounds of them a day for the average 1,000 horse.
The Digestive system of the horse is over 100 feet long. It requires large amounts of water and regular movement of the horse for food that goes into the mouth at the start of the Digestive tract to get through the various organs and multiple twists and turns then out as waste from the anus.
There are many more detailed and technical articles about equine Digestion but my goal, as always, is to help you understand it in a practical sense. Simply, how it works when you feed your horse and how it can be affected when horse owners forget about the importance of water, forage and frequent feedings. I hope it also helps you to understand why I am always preaching about the benefits of a continuous fiber diet for your horse.
Peace and Good Feed,
~The NERD
To receive a PDF version of this article via email for .99 cents click here

Pingback: Equine Nutrition | rodeoworld
Thanks for the shout out RodeoWorld!
Pingback: Equine Nutrition Tip #16 | The Equine Nutrition Nerd
Thank you for this great read, really helped put it all into simple terms!